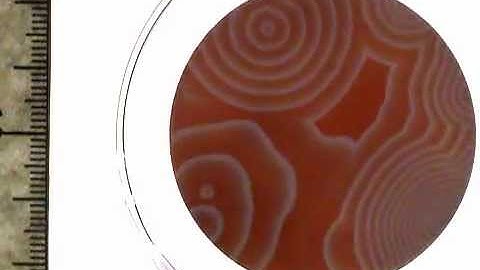
Spatio-temporal pattern of BZ reaction

⬇ DOWNLOAD NOW
Kalau muncul iklan pop-up, tutup lalu klik tombol kembali
Download lagu Bilinear Spatiotemporal Basis Models secara gratis hanya untuk keperluan promosi. Dukung artis favorit kamu dengan membeli musik original di iTunes atau platform resmi lainnya.
 Bilinear Spatiotemporal Basis Models - Fastforward
Bilinear Spatiotemporal Basis Models - Fastforward
 Demo_3D human pose prediction from monocular RGB image
Demo_3D human pose prediction from monocular RGB image
 Spatiotemporal alignment of videos of an object class
Spatiotemporal alignment of videos of an object class
 Modeling human motion as spatiotemporal points, Utah State University
Modeling human motion as spatiotemporal points, Utah State University
 Projection Removal with Fitted Model and Bilinear Interpolation
Projection Removal with Fitted Model and Bilinear Interpolation
 Spatio-Temporal Film Effects
Spatio-Temporal Film Effects
 WACV18: An Order Preserving Bilinear Model for Person Detection in Multi-Modal Data
WACV18: An Order Preserving Bilinear Model for Person Detection in Multi-Modal Data
Spatio-temporal pattern of BZ reaction
Spatio-temporal pattern of BZ reaction